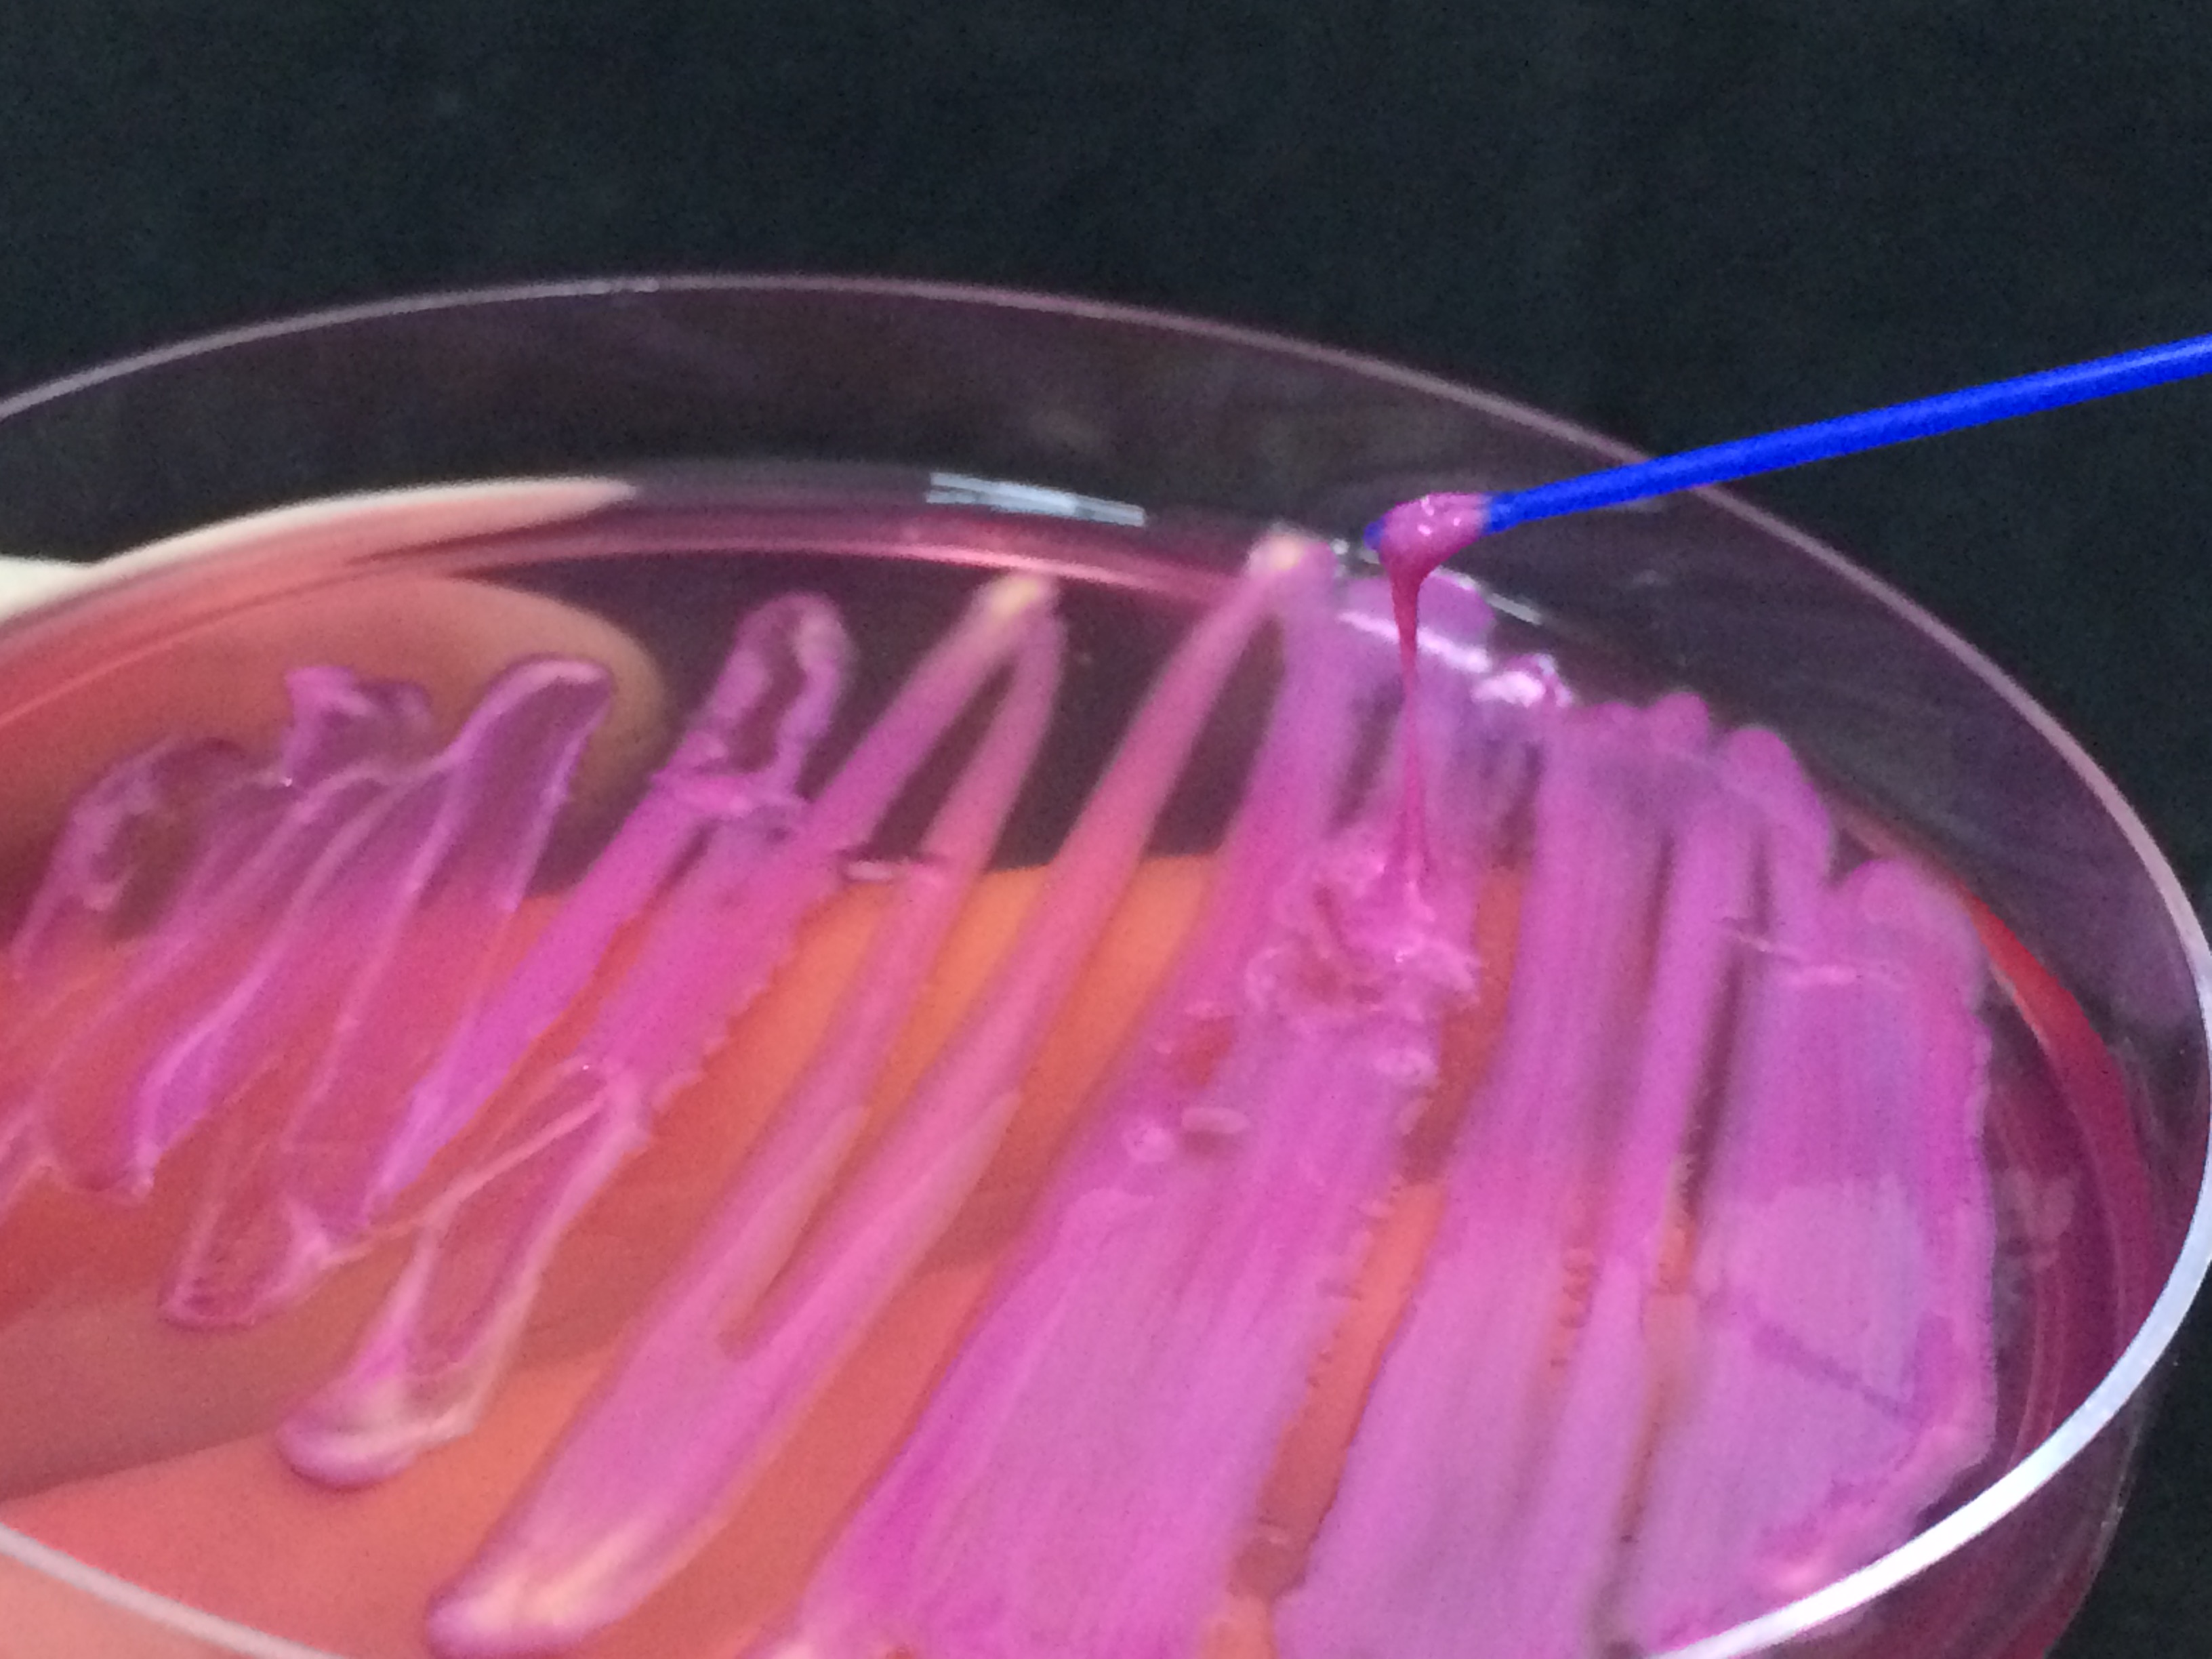

One of the highlights of the next edition of the scientific journal “Clinical Microbiology and Infection”, an important scientific journal in the field of Clinical Microbiology, is a study coordinated by Professor André Pitondo da Silva, a researcher at Unaerp, which consists of the first worldwide report of the bacterium Klebsiella variicola as a cause of primary endodontic infection, popularly known as “tooth canal infection”. The preview of the article can be accessed here.
The research had the collaboration of the researchers Prof. Dr. Yara Terezinha Correa Silva Sousa and Dr. Luciana Martins Domingues Macedo, from the Graduate Program in Dentistry at Unaerp, from doctoral students Rafael Nakamura-Silva and Mariana Oliveira-Silva, from the Graduate Program in Environmental Technology, and from Dr. Louise Cerdeira, researcher at Monash University (Australia).
After a survey of approximately 20 patients at Unaerp Dental Clinic, a place where the research group coordinated by Pitondo carries out several studies, ranging from individual clinical cases to more comprehensive research, the researchers isolated the K. variicola bacterium, causing endodontic infection in one of them. “In addition to having identified an unprecedented species in this type of infection, we discovered that this bacterium had a special characteristic that is called hypermucovisci. The bacteria that have this characteristic grow at the site of the infection with such viscosity that it makes the treatment much more difficult”, explains the researcher.
When identifying this species with the hypermucoid phenotype, the research group decided to deepen the study and entered into a partnership with researchers from the Institute of Biomedical Sciences at USP in São Paulo and from Monash University to carry out the bacterium complete genome sequencing. “With the sequencing, in addition to elucidating the bacterium's genome, we found that it has some virulence genes that contribute to its survival in the host, making treatment difficult. However, the advantage is that the bacterium is totally sensitive to the tested antibiotics, facilitating antibiotic therapy. On the other hand, hypermucoid bacteria have a greater tendency to form bacterial biofilms that hinder the action of the antibiotic at the infection site”, says Pitondo.
For the researcher, the main practical application of this discovery will be in the dental field, as dentists will be more attentive to persistent endodontic infections or with hypermucovisci characteristics, which can aggravate the condition and complicate the treatment. "The knowledge of this type of bacteria in endodontic infections is important for research to be conducted in order to develop specific protocols that make treatment more efficient in these cases", he says.
According to Pitondo, the research raises two important aspects for endodontic treatment. The first is that some infections can be caused by bacteria not commonly reported in this area and more specific techniques are often needed to diagnose them. The other aspect is clinical, because bacteria that have the hypermucovisci phenotype cause a type of infection considered more serious and that can spread to other parts of the body. “The process of cleaning and disinfecting the canal of these teeth is much more difficult, and there may eventually be reinfection, requiring retreatment. In addition, in the upper teeth, this infection can evolve to more serious cases, such as tooth loss, bone loss and even meningitis from sinusitis, which can lead to death” .
It is the first worldwide report of the Klebsiella variicola bacterium as the cause of primary endodontic infection
Prof. Dr. André Pitondo da Silva: "We have identified an unprecedented species in this type of infection"

-
-
- ENGLISH | PORTUGUÊS
- Trabalhe conosco
- Contato
- Acesso Exclusivo
- Acessibilidade
-
CAMPUS RIBEIRÃO|CAMPUS GUARUJÁ